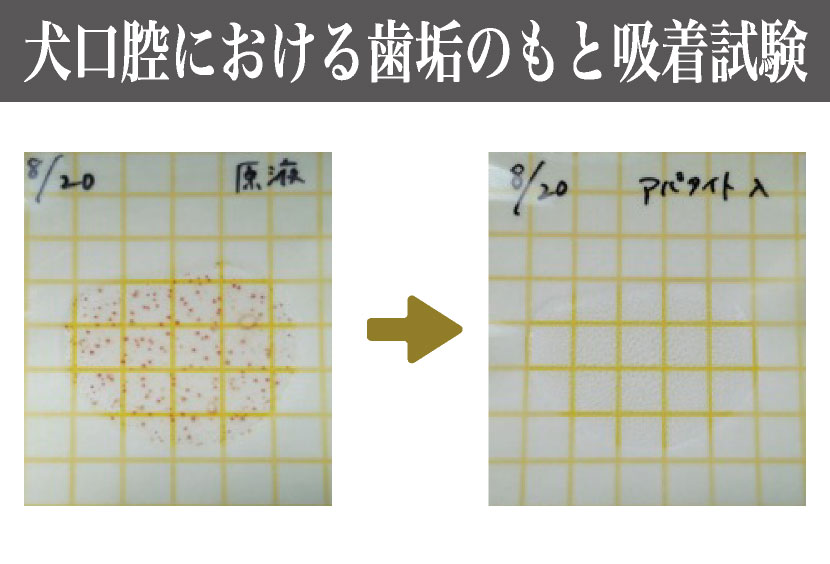
product

吸着して「汚れ、歯垢のもとを落とす」
国内大学の歯学部と共同研究
愛犬の健康を維持。吸着して「汚れ、歯垢のもとを落とす」次世代洗浄剤バイオアパタイト配合「M I G A K E N D E 歯磨き粉」
食品原料としても使われているので飲み込んでも安心です。
オーラルケアを通じて大切なワンちゃんの健康寿命をのばしたい。そんな想いで獣医師に貴重なアドバイスをいただき開発した製品です。

- 着色汚れや歯垢のもとを吸着除去※1
- 卵殻由来のバイオアパタイトの吸着力で、着色汚れや歯垢、口臭の原因となる口内の汚れを吸着除去し※1健やかな口内環境を保ちます。卵の殻が主成分ですがアレルゲンは含まれません。
- 研磨剤不使用・無添加※2
- 研磨剤・発泡剤不使用。歯や歯茎を傷つけない。
- ペーストとジェルの中間タイプ
- 歯ブラシの植毛に留まりやすく唾液の多い犬も洗浄成分が口内に行き届きます。
ミガケンデ 歯磨き粉の使い方
ご使用方法
犬・猫の大きさに合った歯ブラシに適量(約0.4g)を使用して歯を磨いてください。

液体歯磨きとしても使用できます
ペーストの歯磨きに慣れていないまたは唾液の少ないわんちゃんはコップに少量の水(10~30mL)を入れペーストを溶いて歯磨きしてください。
※沈殿物ができたり、完全に水に溶けていなくても問題ありません。
(乾燥して毛が固まる場合があります)

パッケージに記載の使用上の注意・保管上の注意をよくお読みください。
バイオアパタイトとは
バイオアパタイト社が開発し、NIID国立感染症研究所と鶴見大学、慶應義塾大学と共同で研究した次世代のバイオ素材。バイオテクノロジーの技術で、卵殻を用いて製造された独自の卵殻バイオアパタイト。粒子が細かく、肌触りも滑らかで刺激も与えません。様々な分野でも利用が研究されているなど有用性に優れています。
- 環境への配慮
- 日本国内の卵の消費量は年間約2,500,000トン。そのうち約半数が国内卵加工製造食品メーカーで使用されています。卵殻の重量は約10%なので、年間約125,000トンが廃棄物となっています。これを有効活用し、究極のリサイクル原料として高機能なバイオアパタイトを製造しています。
- 汚れの吸着性能
- 歯に付いた黄ばみ、汚れを吸着除去して、歯本来の色を取り戻す、歯垢の原因を除去※1、歯の表面改善効果(特許出願中)、市販のアパタイト(鉱物Ca由来)と比較して3.7倍の有用性があり健やかな歯を持続可能です。
※1ブラッシングの併用による※2合成界面活性剤・合成保存料・合成安定剤、化学合成香料・化学合成色素・鉱物油無添加
- MIGAKENDEミガケンデ⻭磨き粉forDOG
-
- サイズ:縦115mm×横45mm×奥行28mm
- 化粧箱サイズ:縦122mm×横47mm×奥行30mm
- 内容量:40g
- ※1回あたり0.4g使用で約100回使用可能=約3ヶ月分
- タイプ:ソフトタイプ
- ※水で溶くとリキッド状(液体)にもなります。
- 成分について:水、ヒドロキシアパタイト、グリセリン、アルギン酸Na、セルロースガム、ステビア葉/茎エキス、クエン酸Na、フェノキシエタノール
- 使用上の注意
-
- ・ペット(犬や猫等)の口腔ケア以外に使用しないでください。
- ・ペット(犬や猫等)の口内に異常がある時、体調がすぐれな い時には使用しないでください。
- ・ペット(犬や猫等)の体調に 変調が見られた場合は、本品を持参し獣医などの専門医にご相談ください。
- ・生後3ヶ月未満のペット(犬や猫等)にはご 使用にならないでください。
- ・ご使用の際、ペット(犬や猫等) に噛まれないように注意してください。また、チューブ等噛まない様にご注意ください。
- ・ノズルが直接ペット(犬や猫等) に触れないようにしてください。
- ・ノズルが直接ペット(犬や猫等) に触れないようにしてください。
- ・内容物が出にくくなる事がございます。その時は中栓をはずしてお使いください。
- ・ご使用後は必ず中栓をつけてキャップを閉めてください。
- 保存上の注意
-
- ・直射日光や高温多湿を避けて保管してください。
- ・開封後はお早めにご使用ください。
- ・都度中栓をつけてキャップをし っかりお閉めください。
- ・乳幼児の手の届く場所に置かないでください。